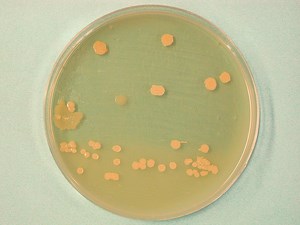
alt

UWAGA! Artykuł pochodzi z 2004 r. By zapoznać się z AKTUALNYMI zaleceniami weterynaryjnymi sprawdź:
Pszczelarskie kompedium wiedzy o zgnilcu amerykańskim cz.1
Pszczelarskie kompedium wiedzy o zgnilcu amerykańskim cz. 2
Pamiętaj by zawsze sprawdzić informacje w nowszych numerach "Pasieki". Wiele informacji z zakresu leczenia pszczół lub gospodarki pasiecznej uległo zmianie. Informacje zawarte w tym artykule utrzymujemy na stronie w ramach archiwizacji wiedzy pszczelarskiej.
Choroby bakteryjne czerwia i pszczół
Zgnilec amerykański
Zgnilec amerykański jest wysoce zaraźliwą chorobą czerwia zasklepionego, rzadziej niezasklepionego, wywołaną przez zarodnikującą bakterię Paenibacillus larvae var. larvae. Znajduje się ona na liście B wykazu chorób zakaźnych OIE i w Polsce podlega obowiązkowi zgłaszania i zwalczania.
Endospory zarazka są oporne na działanie czynników środowiska i powszechnie stosowane środki odkażające. Występują one w ogromnych ilościach w martwym czerwiu, miodzie, pyłku, wewnętrznych ścianach ula i na plastrach pochodzących z rodzin chorych. Wosk i miód działają konserwująco na endospory zarazka. Niszczy je 5-10% roztwór formaliny po 6 godzinach, gorący roztwór sody żrącej po 4 minutach, zaś w wosku i miodzie endospory giną po 30 minutach odkażania w autoklawie.

Bakterie Paenibacillus larvae larvae – preparat mikroskopowy
Głównym źródłem zakażenia i zbiornikiem zarazka jest chory i martwy czerw, miód, pyłek, mleczko pszczele, plastry i wnętrze ula zanieczyszczone endosporami Paenibacillus larvae. Zakażenie szerzy się w rodzinie za pośrednictwem robotnic czyszczących komórki plastra, pielęgnujących czerw oraz przez endospory zanieczyszczające komórki plastra, w których uprzednio przebywał martwy czerw.
Pomiędzy rodzinami i pasiekami roznoszone jest za pośrednictwem pszczół błądzących, rabujących i rojów pochodzących z chorych rodzin, a także plastrów i miodu skażonych endosporami, wstawianych do rodzin zdrowych. Pszczelarz nie przestrzegający zasad higieny pracy w pasiece przyczynia się do rozprzestrzeniania zarazka.
Przenosicielem zakażenia jest też Varroa destructor i szkodniki żyjące w ulu.
Na zakażenie są wrażliwe larwy robotnic, matki i trutni, rzadko choruje i zamiera czerw matek i trutni. Larwy są na nie podatne w wieku do 53 godzin. Z reguły choruje i zamiera czerw zasklepiony w stadium larwy wyprostowanej lub przedpoczwarki, także czerw niezasklepiony zakażony dużymi ilościami endospor oraz czerw o obniżonej na skutek działania stresu odporności.
Nasilenie występowania zgnilca amerykańskiego w pasiekach przypada na schyłek lata i początek jesieni, co może mieć związek z częstymi o tej porze roku rabunkami. Na początku chorują silne rodziny, ponieważ one posiadają w okresach bezpożytkowych szczególne skłonności do rabowania rodzin słabych, w tym chorych.
Oskórek chorego czerwia zmienia zabarwienie z perłowo białego na lekko brązowy, a następnie w miarę postępu choroby na ciemnobrązowy. Segmentacja ciała larwy ulega zatarciu i martwy czerw zmienia się w bezpostaciową masę, która przylega ściśle do ścian komórki plastra i wyciąga się w długie nitki. Martwy czerw po odparowaniu wody zmienia się w „strupek” ściśle przylegający do ścianek komórki plastra. Czerw wydziela charakterystyczny zapach przypalonego rogu. U poczwarek zamarłych na zgnilec amerykański ponad zdezintegrowane ciało wystaje do wnętrza komórki narząd gębowy tworzący charakterystyczny języczek.

Ciemnobrązowa, kleista substancja, w jaką zmienia się ciało
larwy w wyniku namnażania się bakterii, daje się wyciągać w
postaci charakterystycznych nitek – tzw. próba z zapałką
Pierwszym zauważalnym podczas oglądania plastrów objawem choroby są zmiany na zasklepach komórek z martwym czerwiem. Najpierw obserwuje się pojedyncze, a później większą ilość komórek z pociemniałymi i zapadniętymi wieczkami. Niekiedy zasklepy na takich komórkach są podziurkowane, a komórki pozbawione zasklepów. Na zaatakowanych plastrach występuje czerw rozstrzelony.
W chorych rodzinach zmniejsza się ilość czerwia, rodziny słabną, częściej ulegają rabunkom. Na ziemi przed wylotkiem ula znajdują się resztki martwego czerwia, a niekiedy także zdrowy czerw. Z ula wydziela się charakterystyczny zapach przypalonego rogu.
Rozpoznanie choroby o typowym przebiegu jest możliwe na podstawie zmian w chorym i martwym czerwiu. Jednakże w każdym przypadku podejrzenia zgnilca amerykańskiego rozpoznanie kliniczne w pasiece musi być potwierdzone badaniem laboratoryjnym. W tym celu należy pobrać wycinek plastra o wymiarach 10 x 10 cm z zamarłym lub chorym czerwiem (bez miodu).
Do badania mogą być też przesłane martwe pszczoły, pyłek, wosk i miód. Próbki, po dokładnym opakowaniu i oznakowaniu, wraz z pismem przewodnim przesyła się do pracowni chorób pszczół Zakładów Higieny Weterynaryjnej.
Zgnilec amerykański należy do chorób zakaźnych, które podlegają obowiązkowi zgłaszania i zwalczania. Jego zwalczanie obejmuje przesiedlanie rodzin, odkażanie sprzętu, narzędzi, pasieczyska, plastrów, miodu i wosku oraz rąk po pracy w zapowietrzonej pasiece, a także leczenie farmakologiczne. Rzadko stosuje się metodę radykalną, która polega na likwidacji zakażonych rodzin wraz z ulem i jego zawartością.
Nie daje ona efektów tam, gdzie choroba występuje endemicznie. W dużych pasiekach, gdy choroba pojawi się po raz pierwszy i dotyczy niewielkiej liczby rodzin, stosowane jest wysiarkowanie chorych rodzin, spalenie zabitych pszczół wraz z całą zawartością ula oraz jego odkażenie.
Przesiedlanie chorych rodzin ma na celu oddzielenie pszczół dorosłych od chorego i zamarłego czerwia oraz od zanieczyszczonego ula. Wykonuje się je na dwa sposoby: z ula do rojnicy i po głodzeniu do nowego lub odkażonego ula albo bezpośrednio do odkażonego ula na ramki z węzą. W każdym przypadku stosuje się 24 godzinną głodówkę przesiedlanej rodziny, której celem jest usunięcie z przewodu pokarmowego pszczół przesiedlanych endospor zarazka. Dopiero po upływie tego czasu można podać syrop leczniczy.
Przesiedlanie wykonuje się wtedy, gdy istnieje gwarancja, że rodziny przesiedlone zdążą wychować zdrowy czerw i odbudować gniazdo oraz zgromadzić odpowiednią ilość zapasów na zimę. Najlepiej robić to podczas trwania pożytku lub przed pożytkiem głównym.

Objawy kliniczne zgnilca amerykańskiegona plastrze z
czerwiem – czerw rozstrzelony, na zasklepach komórek z
zamarłym czerwiem widoczne otworki wygryzane przez robotnice
Sposoby odkażania omawia załącznik nr 6 do ustawy z dnia 24.IV.1997 O zwalczaniu chorób zakaźnych zwierząt, badaniu zwierząt rzeźnych i mięsa oraz o Inspekcji Weterynaryjnej, tekst ujednolicony wg wersji obowiązującej od dnia 13.II.2002 roku.
Celem odkażania jest zniszczenie endospor zarazka na sprzętach i narzędziach pasiecznych, w pasieczysku i produktach pszczelich (miód i wosk). Musi je poprzedzać mechaniczne oczyszczenie i umycie powierzchni skażonej. Skażone ule, stare lub zniszczone, razem z ramkami i beleczkami oraz ocieplającymi matami należy spalić. W przypadku uli nadających się do dalszego wykorzystania ich wnętrze po mechanicznym oczyszczeniu z resztek kitu i wosku należy opalić ogniem lampy benzynowej do zbrązowienia drewna (na głębokość 2–3 cm). W tym samym celu można ul do połowy wypełnić suchą słomą i ją podpalić.
Alternatywnym sposobem jest wyszorowanie wewnętrznych i zewnętrznych ścian ula i dachu, beleczek, ramek, sprzętu i narzędzi pasiecznych gorącym 2–3% roztworem sody żrącej. Po 15 minutach po zakończeniu odkażania ule, sprzęt i narzędzia myje się czystą wodą lub wodą z dodatkiem octu (2 łyżki stołowe octu/l wody). Nadstawki, beleczki i ramki spala się lub odkaża przez opalanie lub gotowanie w 2% roztworze sody żrącej.
Pasieczysko przed ulami zakażonymi po posypaniu wapnem palonym lub zlaniu 20% mlekiem wapiennym przekopuje się do głębokości 30 cm. Plastry z zakażonym czerwiem należy spalić, a pozostałe plastry z chorych rodzin przetopić na wosk, który trzeba dostarczyć do wytwórni węzy z informacją, że pochodzi z rodzin chorych na zgnilec amerykański. Miód pochodzący z chorych rodzin nie może być wykorzystany do podkarmiania. Może być użyty do produkcji miodów spożywczych lub wyrobów cukierniczych. Endospory zarazka giną w woszczynie poddanej autoklawowaniu. Ręce po pracy w pasiece należy odkazić 1% roztworem sody żrącej, 2% roztworem lizolu lub denaturatem, a następnie dokładnie umyć wodą z mydłem.

Wygląd wnętrza komórki plastra wypełnionej ciemnobrązową masą,
w pełni rozwinięty proces chorobowy zgnilca amerykańskiego
W Polsce jest dopuszczone leczenie zgnilca amerykańskiego przy użyciu polisulfamidu lub oksytetracykliny. Polisulfamid w ilości 0,5 g substancji aktywnej /l syropu cukrowego (1:1) lub oksytetracyklinę w ilości 0,3 g /l w syropu cukrowego (1:1) podaje się rodzinom przesiedlonym po 24 godzinnej głodówce. Syrop leczniczy, każdorazowo w ilości 1 l, stosuje się trzykrotnie w odstępach 4 dniowych. Jednocześnie rodzinom, które mogły ulec zakażeniu, podaje się trzykrotnie w odstępach 4 dniowych po 1 l syropu cukrowego z dodatkiem 0,3 g sulfonamidów/l lub 0, 2 g oksytetracykliny/l.
Według dyrektyw Unii Europejskiej w zgnilcu amerykańskim nie należy stosować chemioterapeutyków, ale ograniczyć się do profilaktyki, odkażania i przesiedlania rodzin. W zgnilcu amerykańskim ogromne znaczenie odgrywa profilaktyka. Obejmuje ona przestrzeganie zasad higieny w pasiekach, okresową kontrolę ich stanu zdrowotnego, kontrolę wędrówek na pożytki, ograniczenie rabunków, nadzór sanitarny nad produkcją węzy, kontrolę importu pszczół, rojów, plastrów z czerwiem, mateczników oraz matek łącznie z posiadaniem weterynaryjnego certyfikatu. Miód pszczeli w obrocie międzynarodowym musi posiadać świadectwo zdrowia (Health certificate for honey)
ZGNILEC EUROPEJSKI
Kolonie Paenibacillus larvae larvae wyhodowane na podłożu
wzrostowym BHIT
W martwym czerwiu zarazek ginie po około 13 miesiącach, w miodzie i na plastrach przeżywa około 1 roku. 2-3% ług sodowy niszczy zarazek po 5 minutach. Wśród mikroflory towarzyszącej duże znaczenie ma Enterococcus faecalis, który rozmnaża się obficie tylko w organizmie czerwia zakażonego i nadaje martwemu czerwiowi kwaśną woń oraz Paenibacillus alvei, który, rozmnażając się wyłącznie na martwym czerwiu, powoduje jego szybkie gnicie i wydzielanie zapachu gnijącego mięsa.
Zarazek po wniknięciu do przewodu pokarmowego zasiedla jelito środkowe, szybko się w nim rozmnaża, często wypełnia prawie całe światło jelita.
Część chorych larw zostaje wykryta przed zasklepieniem komórek plastra i usunięta przez robotnice, część nie. Te ostatnie giną po 3–4 dniach od zakażenia. Pewien procent larw chorych zostaje zasklepiony i ginie przed przepoczwarczeniem, a część przeżywa zakażenie i przechodzi dalsze etapy metamorfozy. Wygryzione z nich pszczoły mogą mieć mniejsze rozmiary aniżeli wygryzione ze zdrowego czerwia. Larwa podczas ruchów ciała zanieczyszcza wnętrze komórki kałem zawierającym zarazek.
Choroba szerzy się pomiędzy pasiekami za pośrednictwem pszczół błądzących i rabujących pochodzących z chorych rodzin, zanieczyszczonych wodopojów, sprzętów i narzędzi pasiecznych, plastrów z chorych rodzin, szkodników żyjących w ulu, a także za pośrednictwem pszczelarza, który nie przestrzega zasad higieny pracy w pasiece.

w badaniach laboratoryjnych do hodowli kolonii
bakteryjnych na sztucznych podłożach wzrostowych
Oskórek chorej larwy traci połysk i zmienia zabarwienie z perłowo białego na żółte. Przez przezroczysty oskórek prześwieca układ tchawkowy i skupiska paciorkowca w jelicie środkowym. Czerw zamiera w różnych pozycjach w komórce. Zwykle ginie na 1-2 dni przed zasklepieniem komórki, czasem zaraz po zasklepieniu, zwykle przed przepoczwarczeniem. Ciało martwego czerwia zmienia się w śluzowatą, zabarwioną na brunatno masę o gumiastej konsystencji, nie wykazującą takiej ciągliwości jak w przypadku zgnilca amerykańskiego. Po odparowaniu wody zmienia się ono w ciemnobrązowy strupek łatwo usuwalny z komórek plastra.
W przypadku powikłania zakażenia przez Paenibacillus alvei oprócz czerwia niezasklepionego ginie także zasklepiony. Wtedy wieczka zasklepów są wilgotne i zapadnięte, a pszczoły wygryzają otworki w zasklepach, przez które usuwają martwy czerw. Na plastrach występuje czerw rozstrzelony. Z ula wydobywa się zapach gnijącego mięsa.
Gdy robotnice efektywnie wykrywają i usuwają chory i martwy czerw, a tym samym ograniczają rozmnażanie i rozsiewalność Melissococcus pluton, zakażenie może utrzymywać się niezauważone przez kilka lat. Z chwilą, gdy pszczoły nie nadążają z usuwaniem chorego i martwego czerwia, co ma miejsce wczesną wiosną i wczesnym latem, kiedy szybko przybywa czerwia, następuje wybuch choroby. Rodzina szybko słabnie i staje się ospała, jej produkcyjność spada, często występują rabunki. Duży ubytek pszczół w rodzinie będący następstwem zamierania czerwia może doprowadzić przy ciężkim przebiegu zgnilca europejskiego do likwidacji rodziny.
Rozpoznanie choroby opiera się o objawy kliniczne i badanie laboratoryjne. W przypadku podejrzenia zgnilca europejskiego istnieje obowiązek przesłania do badania laboratoryjnego wycinka plastra z chorym i martwym czerwiem.
Zapobieganie chorobie polega na zapewnieniu rodzinom odpowiednich warunków chowu, żywienia i higieny. W tym celu w pasiece należy trzymać silne rodziny, zabezpieczyć gniazdo przed oziębieniem przez dostosowanie wielkości gniazda do siły rodziny oraz dodatkowe ocieplenia w przypadku dużych spadków temperatury. Należy przestrzegać zasad higieny, zapewnić stały dopływ pokarmu i czystej wody, ograniczyć czerwienie matki w okresie zmniejszenia pożytku, unikać przeglądów gniazda w okresie chłodów, okresowo kontrolować stan zdrowia rodziny, zapobiegać rabunkom i błądzeniu pszczół, eliminować z chowu matki pochodzące z chorych rodzin.
W Polsce postępowanie lecznicze zależy od postaci choroby. W postaci kwaśnej pszczoły otrzymują syrop z dodatkiem 0,5 g oksytetracykliny/l trzykrotnie w odstępach 4 dniowych. Po ostatnim miodobraniu można stosować streptomycynę w ilości 0,5 g/l syropu w identyczny sposób jak w przypadku oksytetracykliny.
W ciężkiej postaci choroby należy pszczoły przesiedlić do nowego lub odkażonego ula i leczyć po 24 godzinnej głodówce. Odkażanie w zgnilcu europejskim przeprowadza się w sposób identyczny jak w zgnilcu amerykańskim
{/f90filter}prof. Zdzisław Gliński
